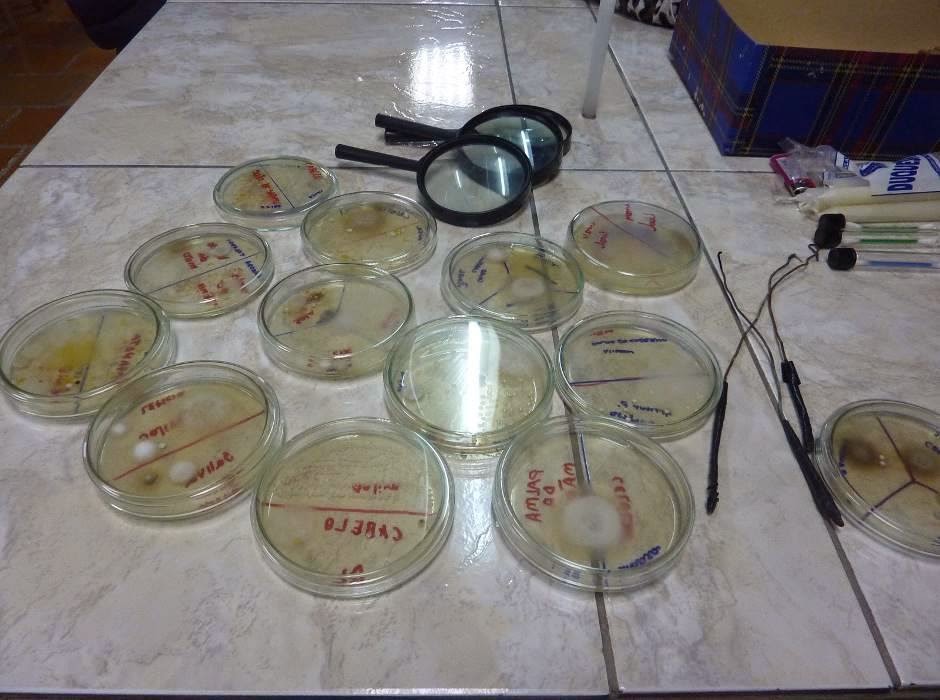

REINO MONERA
Durante o período de 23/06 a 07/07 foram realizadas duas atividades práticas sobre o Reino Monera com 7 turmas de 2º ano do segundo grau do Colégio Imigrante abrangendo um total de 165 alunos.
As atividades foram:
“Produção de Iogurte”, “Cultivo de bactérias – bactérias no ambiente e
bactérias em superfícies”. Os roteiros foram elaborados em conjunto por todos
os integrantes do Pibid que atuam no colégio Imigrante, juntamente com a
professora Supervisora com o objetivo de fixar o conteúdo e estabelecer uma
relação entre o conteúdo e o cotidiano dos alunos.
Início
da prática de iogurte, onde os monitores estavam a presentando os materiais que
seriam utilizados e realizando a assepsia das mãos e das bancadas a serem
utilizadas.
Créditos: Pibid-Biologia-Caxias do Sul
Alunos preparando o Iogurte.
Créditos: Pibid-Biologia-Caxias do Sul
Alunos, ao final da prática,
provando o iogurte produzido pelos Pibidianos.
Créditos: Pibid-Biologia-Caxias
do Sul.
CULTIVO DE BACTÉRIAS -
BACTÉRIAS NO AMBIENTE E EM SUPERFÍCIES
Para a realização desta atividade prática, a coordenação do Curso de Ciências Biológicas da Universidade de Caxias do Sul, juntamente com o Projeto PIBID/Biologia disponibilizou 150 placas de Petri, devidamente preparadas com Agar, bem como os cotonetes para as coletas, devidamente esterilizados. Com o objetivo de entender a relação das bactérias na vida dos seres humanos - Conhecer os benefícios e malefícios das bactérias.
Pibidianos explicando o
procedimento da coleta do material biológico.
Créditos: Pibid-Biologia-Caxias
do Sul.
Créditos: Pibid-Biologia-Caxias do Sul.
RELAÇÕES ECOLÓGICAS (1º ano do ensino médio politécnico)
Na primeira semana de agosto, foi
iniciado nos primeiros anos do ensino médio o conteúdo sobre relações
ecológicas, o mesmo resume-se em seres vivos de uma mesma comunidade que
relacionam-se entre si e com o meio. Tal interação ocorre não só entre
indivíduos da mesma espécie (relações intraespecíficas), mas também de outras
populações (relações interespecíficas); podendo consistir em laços benéficos,
ou não. O conteúdo foi aplicado de forma diferenciada visando facilitar o
aprendizado, tornando-o mais interessante para os alunos.
Maquetes sobre relações
ecológicas “Herbivoria” construídas pelos Pibidianos
Créditos:
Pibid-Biologia-Caxias do Sul.
REINO PROTISTA (2º ano do ensino médio politécnico)
O reino Protista ilustra um
imenso laboratório experimental para a evolução de outros seres vivos mais
complexos, devido a sua diversidade de organismos com estrutura altamente
especializados. Os protistas são eucariontes, a maioria unicelular e estão
representados por dois grupos básicos: fitoplâncton (algas) e zooplâncton
(protozoários). Assim, a proposta educacional para se trabalhar
o reino Protista foi à elaboração de mapas conceituais. Mapas conceituais são
diagramas que demonstram de forma diferenciada conteúdos. Esta forma de se
trabalhar inclui um preparo e bom entendimento, pois sua estrutura geralmente
segue uma hierarquia de conceitos e suas delimitações.
Alunos confeccionando os Mapas
Conceituais.
Créditos: Pibid-Biologia-Caxias do Sul.
REINO FUNGI
Os
fungos são organismos eucariontes que apresentam nutrição heterotrófica, ou
seja, não conseguem produzir seu próprio alimento. Algumas espécies de fungos
trazem grandes prejuízos aos seres humanos, como a deterioração de alimentos,
doenças como candidíase, micoses e sapinho, porem outras espécies de fungos são
amplamente utilizados na gastronomia, além disso, há os que são utilizados na
indústria alimentícia e de bebidas, os fungos também são muito importantes na
indústria farmacêutica, na produção de antibióticos como a penicilina.
Atividade prática do Reino Fungi.
Créditos: Pibid-Biologia-Caxias do Sul.
REINO PLANTAE (2º ano do ensino médio politécnico)
A preservação do meio ambiente é
muito importante para que possamos ter no futuro, um mundo mais limpo e rico
em recursos naturais. A preocupação com o meio ambiente e a conscientização
deve envolver toda a sociedade, inclusive crianças e adolescentes que devem
observar o meio ambiente com curiosidade, percebendo-se como ser integrante,
dependente, transformador e, acima de tudo, que tem atitudes de conservação.
A atividade proposta visa à
conscientização dos alunos para com o meio ambiente, o professor pode abordar
temas como a importância da água para os seres vivos, como a semente germina, como
as atividades humanas podem interferir no meio ambiente, por que o meio
ambiente depende de nós, entre tantos outros assuntos. É uma atividade
interessante que desperta a consciência dos alunos para a ecologia, além de
dar-lhes a oportunidade de cuidar de um ser vivo
.
Através do lúdico os alunos podem
observar o crescimento das plantas. Os bonecos ainda auxiliam no estudo dos
seres com vida e sem vida. Feitos de meia calça contém terra e/ou areia e
sementes de alpiste dentro. Por fora, os bonecos podem ser enfeitados e
caracterizados com olhos, nariz, boca e orelhas criando fisionomias diferentes.
Os alunos podem acompanhar o crescimento das sementes de alpiste brotando e
formando o cabelo do boneco molhando-os diariamente.
Resultado final do experimento
cuca-verde de alguns alunos.
Créditos: Pibid-Biologia-Caxias do Sul
Fototropismo (Labirinto de Feijões)
As plantas crescem tão lentamente
que só podemos identificar os seus movimentos ao longo do tempo. Elas sabem o
caminho por onde devem crescer com base na luz, na água e na gravidade. Seus
sutis movimentos em direção às coisas de que precisam são chamados
"tropismos". A projeção de uma planta em direção à luz é chamada de
fototropismo. Uma caixa de sapatos é um espaço ideal para plantar uma pequena
planta e observar como ela usa a luz e um hormônio vegetal chamado auxina para
crescer em sua direção, ilustrando o fototropismo.
Vista superior do labirinto de
feijões produzido pelos alunos.
Créditos: Pibid-Biologia-Caxias do Sul
Herbário
O Reino Vegetal apresenta um
conteúdo extenso e muitas vezes longe do contexto dos alunos, causando assim,
desmotivação com a abordagem. A compreensão e aprendizagem das aulas de
botânica, exige a aplicação de atividades práticas, para que possam unir o
conhecimento teórico ao prático.
O Herbário pode participar na
integração das pesquisas sobre a diversidade florística e o inventário
sistemático do patrimônio vegetal, essencial para apontar os remanescentes de
vegetação nativa com potencial para preservação, bem como subsidiar com mais
rigor os estudos que possibilitem o reflorestamento de áreas.
Herbários construídos pelos
alunos.
Créditos: Pibid-Biologia-Caxias do Sul
CITOLOGIA
Nosso projeto foi elaborado com
orientação da professora supervisora Arlene Calai junto com a professora de
artes. O tema escolhido foi a célula, pois se identifica mais com o
entendimento de outros temas relacionados com a vida animal. Essa estrutura é à
base do entendimento de assuntos ligados a ciência. Foi proposta uma atividade
de confecção de uma célula eucariota para que os alunos contemplem o conteúdo
teórico junto com uma atividade prática.
A construção dos modelos faz com
que os estudantes se preocupem com os detalhes dos mesmos e a melhor maneira de
representá-los, pois quando se constrói, se revisa o conteúdo e se observa
também as habilidades artísticas do aluno. As maquetes, como estruturas
tridimensionais (alto relevo) e coloridas são utilizadas como facilitadoras do
aprendizado. Além do lado visual, esses modelos permitem que o estudante
manipule o material, visualizando-o de vários ângulos a própria construção dos
modelos.
Créditos: Pibid-Biologia-Caxias do Sul